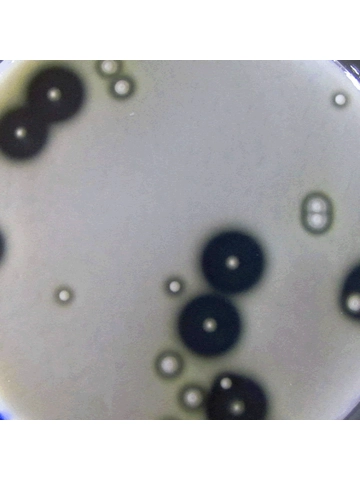
100g  Milk Agar

1363 product(s) found for Lab Chemicals
100 gram 5-Sulfosalicylic acid dihydrate 99%
£22.59
5-Sulfosalicylic acid dihydrate is a sulfonated salicylic acid derivative. Strong association with a range of metals makes 5-Sulfosalicylic acid useful as a metal scavenger. It forms proton-transfer dye...
100 ml Bromobutane 99%
£13.30
Minimum Assay: 98% Molecular Formula: C4H9Br Molecular Weight: 137.03 Melting Point: -112 C Boiling Point: 101-102 C Refractive Index: 1.440 Density: 1.275 Hazard Phrases: Highly flammable liquid and vapour....
100g L(+) Ascorbic Acid 99-100.5% BP,USP,FCC
£7.91
L(+) Ascorbic Acid, also known as Vitamin C, is a naturally occurring organic compound that plays a vital role in many biological processes. It is a white, crystalline powder that is water-soluble and...
100g Milk Agar
£19.92
For the enumeration of micro-organisms in milk, rinse waters and dairy products. With the addition of a further 5g/l MC002 Agar No. 1 the medium is suitable for the preparation of Roll-Tubes using established...
100g Mono Sodium Phosphate Anhydrous Food Grade
£9.66
Monosodium phosphate (MSP), also called sodium dihydrogen phosphate or sodium phosphate monobasic, is a multifunctional ingredient that can be used as an acid regulator, sequestrant and nutrient supplement...
100g Zinc Chloride >98%
£9.99
Zinc chloride is the name of chemical compounds with the formula ZnCl2 and its hydrates. Zinc chlorides, of which nine crystalline forms are known, are colourless or white, and are highly soluble in water....
100g Acridine Orange 50% C.I. 46005
£228.45
Acridine orange can be used in conjunction with ethidium bromide to differentiate between viable, apoptotic and necrotic cells. Additionally, Acridine orange may be used on blood samples to fluoresce bacterial...